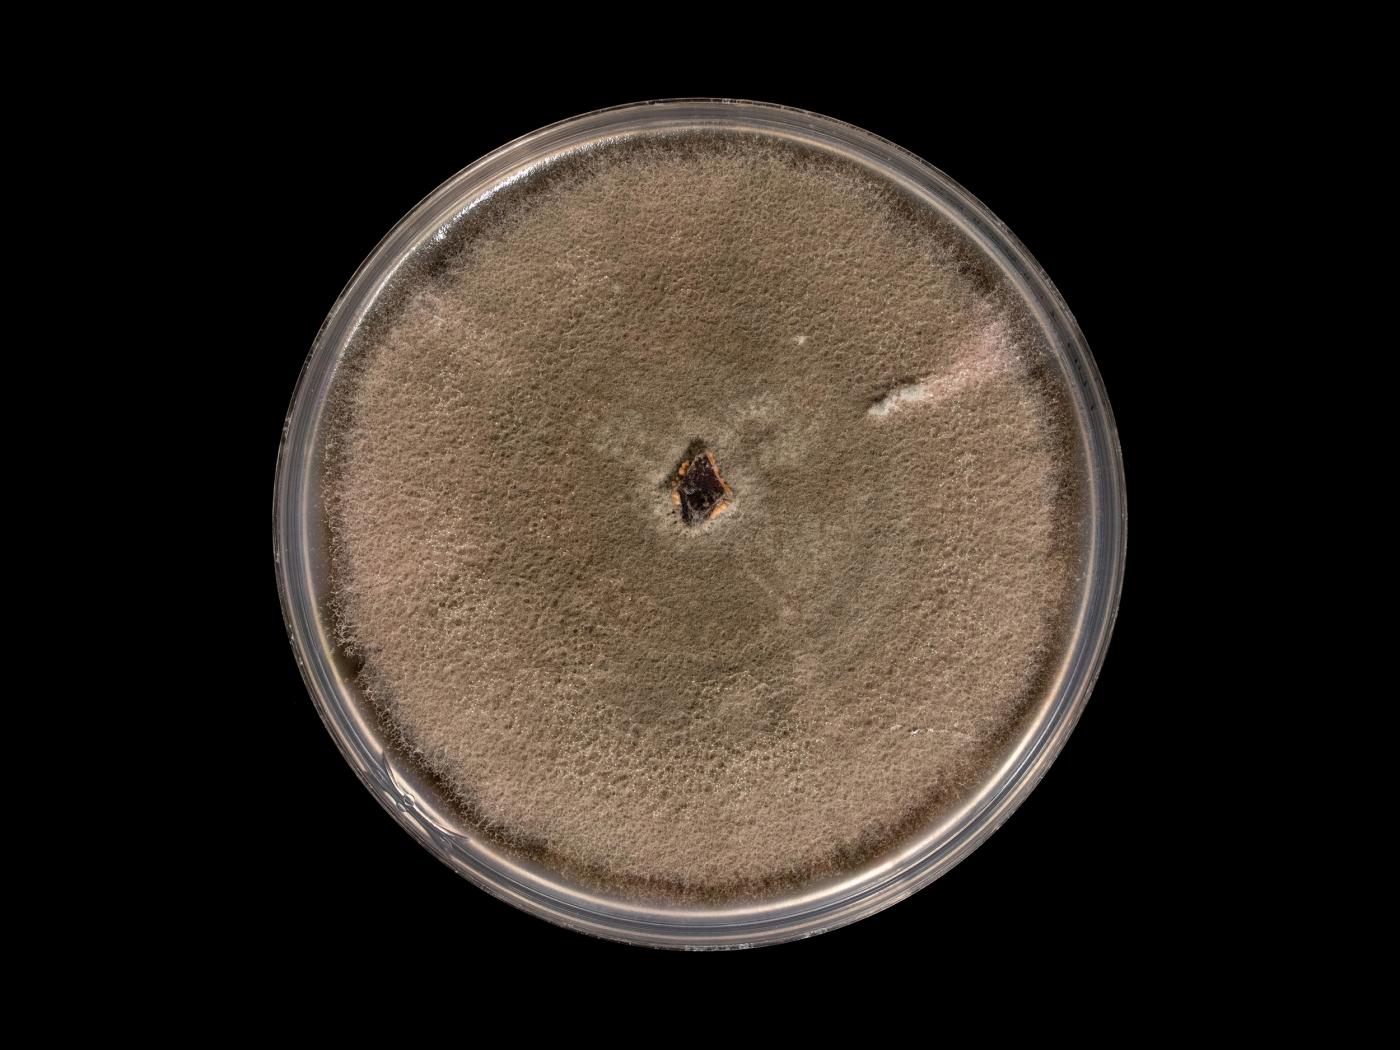

Suite à de nombreuses études réalisées par divers chercheurs, Colletotrichum acutatum s'est révélé être un complexe d'espèces vu la grande diversité morphologique.
Colletotrichum acutatum cause l'anthracnose chez de nombreuses cultures, mais la fraise est la culture la plus économiquement touchée.
Sur le milieu de culture SNA :
Mycélium : les hyphes sont hyalins, lisses, septés et ramifiés. Diamètre : 1-5,5 μm
Fructification : aucun acervule. Sur la plante hôte, acervule avec de rares setae.
Conidies : Cylindriques à fusiformes aux apex aigus (pointus). À parois droites et lisses. Sans septation (amérospores). Parfois guttulées. Hyalines si seules; rose saumon si regroupées en amas (exsudat conidien). Dimension : 11-14,5 × 3,5-4 µm. Dimension (sur la plante hôte) : 12-16,5 × 3,5-4,5 µm.
Conidiophores : Toujours hyalins et à parois lisses. Les conidiophores sont formés directement sur le mycélium. Ils sont non septés (= simples) et non ramifiés ou parfois septés et ramifiés. Courts (longueur : jusqu'à 25 µm). Sur la plante hôte, les conidiophores sont formés sur un coussin constitué de cellules angulaires brun pâle. Ils sont septés et ramifiés. Longs (jusqu'à 50 µm).
Cellules conidiogènes : Phialides hyalines, cylindriques ou légèrement renflées, lisses, sans septation, avec une collerette distincte. Dimension : 3,5-20 × 2-3,5 µm. Dimension (sur la plante hôte) : 9-18 × 3-3,5 µm.
Microsclérotes : Absents (c’est l'une des rares espèces de Colletotrichum qui ne produit pas de microsclérotes).
Appressoria : Présence d'appressoria solitaires bruns. Claviformes (en forme de massue) ou ovoïdes. Dimension : 6,5-11 x 4,5-7,4 µm. Visibles en dessous des mises en culture.
La forme des conidies de C. acutatum, C. coccodes et C. gloeosporioides peuvent se ressembler.
Cultures ou autres organismes affectés
Argousier
Argousier - Anthracnose (Colletotrichum acutatum)_2
Argousier - Anthracnose (Colletotrichum acutatum)_3
Argousier - Anthracnose (Colletotrichum acutatum)_4
Argousier - Anthracnose (Colletotrichum acutatum)_5
Céleri
Céleri - Anthracnose (Colletotrichum acutatum)_2
Céleri - Anthracnose (Colletotrichum acutatum)_3
Céleri - Anthracnose (Colletotrichum acutatum)_4
Céleri - Anthracnose (Colletotrichum acutatum)_5
Fraise
Fraise - Anthracnose (Colletotrichum acutatum)_2
Fraise - Anthracnose (Colletotrichum acutatum)_3
Fraise - Anthracnose (Colletotrichum acutatum)_4
Fraise - Anthracnose (Colletotrihum spp.) - Cycle de maladie